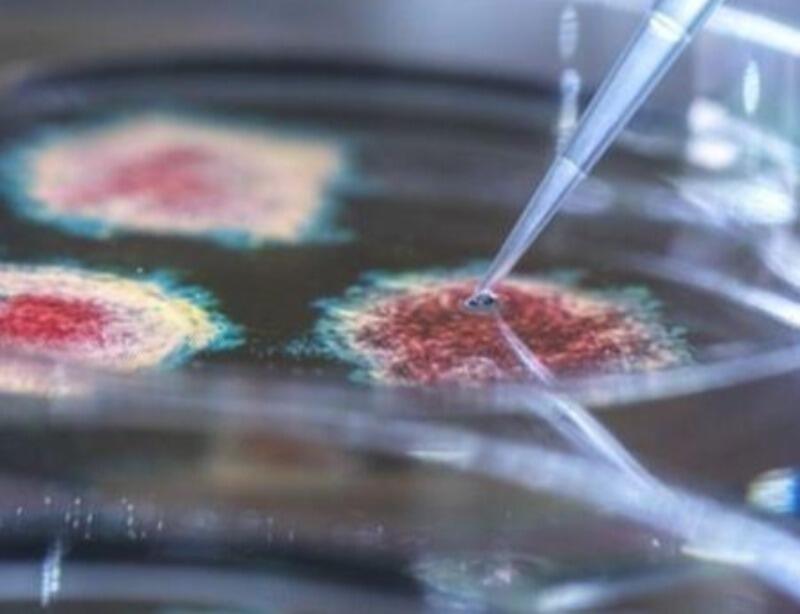

Autoridades de saúde dos Estados Unidos relatam que encontraram um tipo raro, mas perigoso de bactéria em amostras de solo e água na região da Costa do Golfo do Mississippi.
Chamada Burkholderia pseudomallei, ela pode deixar algumas pessoas extremamente doentes se forem infectadas.
Os médicos estão agora em alerta para quaisquer possíveis casos.
A melioidose pode ocorrer em pessoas que têm doenças como diabetes e doença renal crônica. Ela normalmente causa sintomas como febre, dor nas articulações e dores de cabeça, bem como problemas pulmonares e infecções no sangue.
No entanto, a maioria das pessoas saudáveis que entram em contato não desenvolve a doença grave chamada melioidose, que pode ser tratada com antibióticos.
Os Centros de Controle de Doenças dos EUA (CDC) estão aconselhando os residentes que possam estar em maior risco a tomar precauções:
"Dado o número muito pequeno de casos de melioidose identificados historicamente nos Estados Unidos, o CDC acredita que o risco de melioidose para a população em geral continua sendo muito baixo", disse a agência.
Não está claro há quanto tempo está no meio ambiente e onde mais pode ser encontrado nos EUA.
Em todo o mundo, a maioria dos casos ocorre em pessoas que vivem ou viajaram para áreas onde a bactéria ocorre naturalmente, como partes do sul e sudeste da Ásia e norte da Austrália.
Casos de melioidose também foram associados a produtos comerciais contaminados importados de países endêmicos. Isso aconteceu nos EUA em 2021, quando um conjunto de quatro casos em quatro estados foi vinculado a um spray de aromaterapia importado que estava contaminado.
As investigações do solo no Mississippi foram motivadas por dois casos de melioidose em pessoas que não se conhecem e que vivem na região nos últimos anos. A disseminação de pessoa para pessoa é extremamente rara.
Autoridades de saúde testaram amostras de solo e água dentro e ao redor das casas de ambos os pacientes. Três das amostras tiveram resultado positivo para a bactéria, sugerindo que o micro-organismo está presente na área desde pelo menos 2020.
Ceará, Brasil
A melioidose já foi identificada no Brasil. A primeira descrição de um caso autopsiado de melioidose no Ceará foi feita em 2003 e relata o caso de uma adolescente de 14 anos que era sadia até seis dias antes de morrer. Segundo os médicos, "após banho de açude, passou a apresentar febre, calafrios, cefaleia holocraniana (dores ou pressão que envolve toda a cabeça), vômitos pós-prandiais (aqueles que ocorrem após a alimentação), e, dois dias depois, tosse seca persistente e dor no abdome superior".
Depois, "evoluiu rapidamente com hipotensão, insuficiência respiratória e renal, acidose metabólica, choque séptico e óbito".
O relato aponta ainda que dois irmãos também morreram — o primeiro dois dias antes e o segundo dois dias depois, com quadros clínicos semelhantes, todos apresentando uma broncopneumonia grave com sepse (infecção generalizada).
Depois desse primeiro caso em 2003, na zona rural do Município de Tejuçuoca, Ceará, outros casos foram registrados, segundo o governo estadual.
Em uma nota técnica de 2017, as autoridades estaduais alertam que a melioidose simula outras doenças infecciosas e dizem que o diagnóstico e o tratamento devem ser precoces, uma vez que a doença tem letalidade elevada.
Este texto foi publicado em https://www.bbc.com/portuguese/geral-62346295
Por BBC